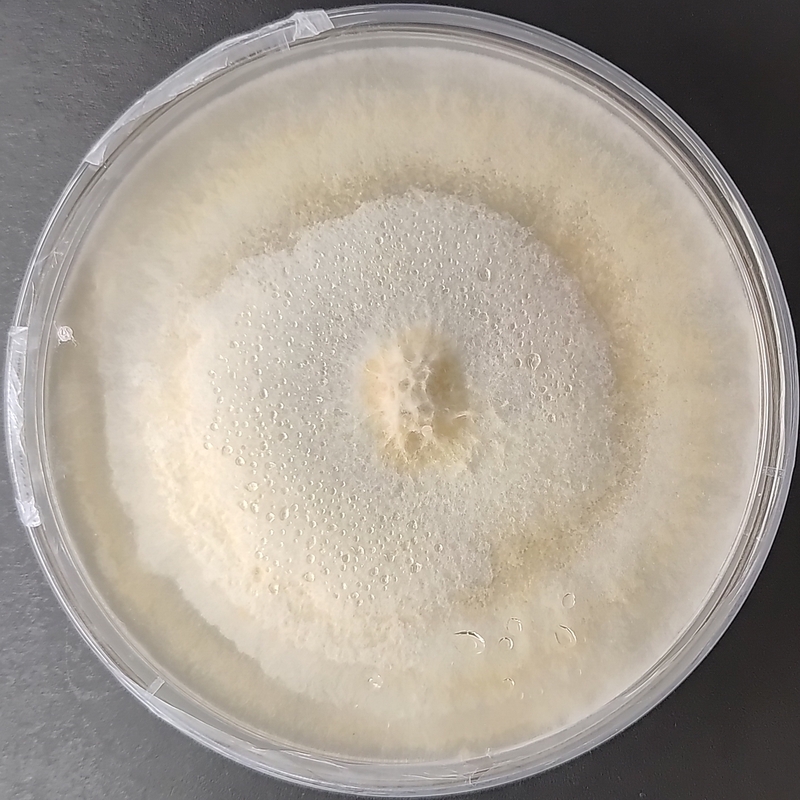

Ceriporus squamosus (Dryad’s Saddle) – Pure Culture Plate
Ceriporus squamosus i.e. Polyporuis squamosus, also known as Dryad’s Saddle or Pheasant Back Mushroom, is a striking wood-decaying fungus found on hardwood logs and stumps. Known for its distinctive scaly pattern and cucumber-like aroma, it’s both a gourmet edible when young and a species of interest for biodegradation and lignin-decomposing research.
This pure culture plate from Agripie provides a research-grade, contamination-free strain ideal for:
Mycological research and teaching labs
Fungal biodiversity and taxonomy studies
Biodegradation and enzyme research
Gourmet mushroom cultivation trials
Agripie ensures that each plate is lab-isolated, quality tested, and ready for subculturing or spawn preparation under sterile conditions.
🌿 Key Features:
100% pure Ceriporus squamosus (Dryad’s Saddle) strain
Sterile, sealed, and contamination-free Petri dish
Excellent for research, education, and applied mycology
Exhibits strong mycelial growth and distinct texture
Quality-assured and packaged by Agripie Mycology Lab
📦 Product Details:
Format: Pure culture on nutrient agar plate
Packaging: Sterile Petri dish, vacuum sealed
Storage: 2–8°C, away from light
Shelf Life: Up to 3 months (under refrigeration)
Origin: Agripie Mycology Laboratory, India

|
| 
